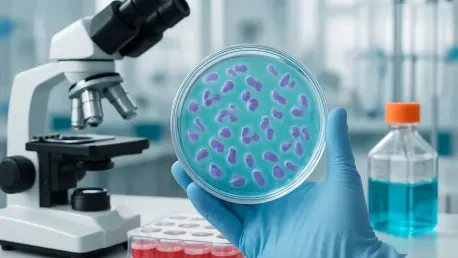

In the high-stakes arena of biopharmaceuticals, where the race to deliver life-saving therapies to patients is intensifying, a transformative collaboration between Abzena, Revvity, and ProteoNic Bioscience is making waves with significant upgrades to biomanufacturing processes. This partnership has ushered in a major enhancement to Abzena’s AbZelectPRO cell line development (CLD) platform, promising to redefine the pace and efficiency of therapeutic protein production. With the integration of cutting-edge technologies, this advancement addresses a critical industry demand for accelerated timelines, ensuring that groundbreaking treatments reach the market sooner. The enhanced platform not only tackles speed but also prioritizes scalability and cost-effectiveness, positioning it as a vital tool for biopharma companies navigating an increasingly complex landscape. As the sector continues to evolve with diverse therapeutic modalities, such innovations are essential for staying competitive and meeting patient needs with precision and agility.
Innovations in Cell Line Development
Speed and Productivity Gains
The most striking feature of the upgraded AbZelectPRO platform lies in its ability to drastically shorten biopharmaceutical development timelines, a factor that can make or break market success. By incorporating two new glutamine synthetase (GS) knockout Chinese hamster ovary-K1 (CHO-K1) expression systems—known as AbZelectPRO-KO and AbZelectPRO-KO+—the platform reduces the journey from DNA to research cell banks to an impressive 10 weeks. This rapid turnaround is a significant leap forward in an industry where delays can cost millions and hinder patient access to therapies. Furthermore, the system achieves protein titers of up to 10 grams per liter, setting a high bar for productivity. Such efficiency ensures that developers can produce substantial quantities of therapeutic proteins in record time, streamlining the path from lab to clinic.
Beyond the headline-grabbing timeline reduction, this advancement signals a shift in how biopharma companies can approach early-stage development with confidence. The high titers achieved by the platform mean that even smaller-scale operations can yield commercially viable outputs without requiring extensive resources or prolonged processes. This productivity boost is particularly beneficial for emerging biotech firms that often operate under tight budgets and aggressive schedules. Additionally, the integration of Revvity’s proven CHOSOURCE technology with ProteoNic’s innovative tools ensures that these gains are reliable and reproducible, providing a stable foundation for consistent results across diverse projects. This reliability is crucial for maintaining quality standards as production scales up, addressing a key concern in biologics manufacturing.
Versatility for Complex Therapies
Another cornerstone of the enhanced platform is its remarkable adaptability to a wide array of protein modalities, catering to the evolving needs of the biopharma pipeline. Whether dealing with therapeutic antibodies, bispecific antibodies, or other next-generation biologics, the GS knockout CHO-K1 systems are engineered to handle even the most challenging and hard-to-express proteins. This versatility is vital as the industry increasingly focuses on complex therapies that require tailored manufacturing solutions. By offering a platform that can seamlessly adapt to various protein types, Abzena ensures that developers are not constrained by technical limitations, enabling innovation in drug design without the fear of production bottlenecks.
Equally important is how this flexibility positions the platform to support future therapeutic trends, where diversity in molecular structures is becoming the norm. As biopharma companies explore novel formats to address unmet medical needs, having a manufacturing system that can pivot to accommodate unique requirements is a competitive advantage. The ability to produce afucosylated proteins, for instance, enhances immune effector functions in therapeutic antibodies, aligning with the growing demand for treatments with improved efficacy. This forward-thinking design not only meets current demands but also anticipates the challenges of tomorrow, ensuring that the platform remains relevant as the therapeutic landscape continues to shift and expand.
Economic and Scalability Benefits
Cost-Efficiency in Manufacturing
A critical advantage of the revamped AbZelectPRO platform is its focus on driving down the cost of biologics production, a persistent pain point for the industry. By optimizing expression efficiency through advanced GS knockout systems, the platform significantly reduces the cost of goods, making it more feasible for developers to scale operations without incurring prohibitive expenses. This cost-efficiency is particularly impactful during the transition from research to commercial production, where financial constraints often limit progress. Lowering these barriers allows companies to allocate resources to other critical areas, such as clinical trials or regulatory compliance, ultimately accelerating the delivery of therapies to patients.
Moreover, the economic benefits extend to enhancing overall manufacturing reliability, ensuring that quality remains uncompromised even as costs decrease. The integration of cutting-edge vector technology from ProteoNic plays a pivotal role in achieving consistent yields, minimizing waste, and reducing the need for costly rework. This streamlined approach addresses long-standing inefficiencies in biologics production, where variability in output can lead to significant financial losses. For biopharma firms under pressure to meet growing global demand, this platform offers a practical solution to balance affordability with the stringent quality standards required in therapeutic development, fostering sustainable growth in a competitive market.
Scalability for Market Demands
Scalability stands as another defining feature of this innovative platform, designed to support biopharma companies through every stage of drug development. From early research to full-scale commercial supply, the system’s modular framework allows for seamless expansion without the disruptions often associated with scaling up. This capability is essential in an industry where demand for biologics can surge unexpectedly, driven by breakthroughs in treatment or sudden public health needs. The platform’s design ensures that manufacturers can ramp up production swiftly, maintaining a steady supply chain even under intense market pressures.
Equally significant is how this scalability aligns with the need for precision in meeting specific production volumes, avoiding overproduction or shortages. The flexibility to adjust output based on real-time requirements helps mitigate risks associated with forecasting errors, a common challenge in biomanufacturing. By providing a reliable infrastructure for growth, the platform empowers companies to respond to market dynamics with agility, ensuring that therapeutic innovations reach patients without unnecessary delays. This adaptability not only enhances operational efficiency but also builds trust with stakeholders who rely on consistent access to high-quality biologics.
Industry Trends and Collaborative Efforts
Power of Partnership
The collaboration between Abzena, Revvity, and ProteoNic exemplifies a growing trend in biopharma where pooling expertise is key to overcoming multifaceted manufacturing challenges. By combining Revvity’s widely trusted CHOSOURCE GS knockout expression systems with ProteoNic’s 2G UNic vector technology, the partnership creates a robust solution that no single entity could achieve alone. This synergy highlights the value of integrated workflows, where cell line engineering, vector optimization, and downstream processing converge to streamline development cycles. Such collaborative innovation is rapidly becoming a cornerstone of progress in the field.
This alliance also reflects a broader industry shift toward shared problem-solving, where specialized knowledge from multiple stakeholders drives efficiency. The success of this joint effort serves as a model for how strategic partnerships can tackle complex issues like timeline compression and productivity enhancement. By leveraging each partner’s strengths, the resulting platform not only addresses immediate needs but also sets a precedent for future collaborations. This approach ensures that the biopharma sector continues to evolve through collective advancements rather than isolated efforts, fostering a more resilient and innovative ecosystem.
Adapting to Future Needs
Looking ahead, the platform’s alignment with modular and agile manufacturing strategies positions it to meet emerging therapeutic and regulatory demands with ease. Its adaptable design supports seamless transitions across development phases, ensuring that biopharma companies can respond swiftly to new opportunities or compliance requirements. This forward-thinking approach is crucial as the industry navigates an era of rapid change, with novel therapies and stricter guidelines shaping the future. The ability to pivot without overhauling existing systems offers a significant edge in maintaining competitiveness.
Additionally, the emphasis on specialized technologies, such as afucosylated protein production, underscores a commitment to staying ahead of therapeutic trends. As the demand for treatments with enhanced immune functions grows, platforms equipped to deliver such capabilities will be indispensable. This adaptability extends to addressing global supply challenges, where flexible manufacturing can bridge gaps in access to critical therapies. By anticipating these shifts, the enhanced platform not only solves current problems but also lays the groundwork for sustained relevance, ensuring that biopharma innovation keeps pace with an ever-changing landscape.